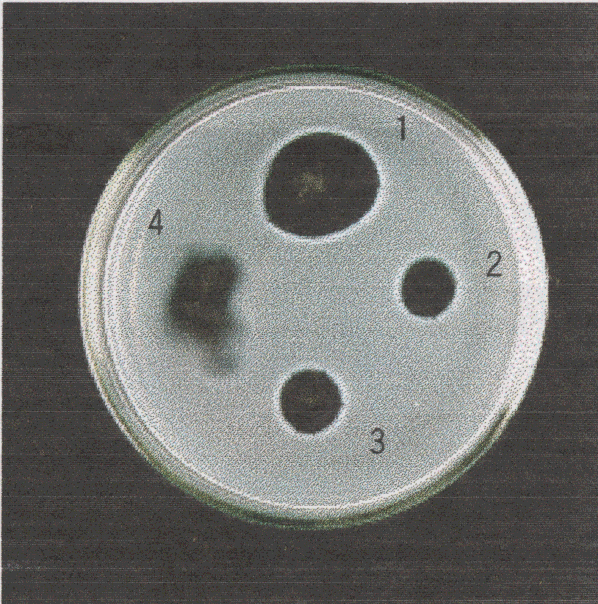

It was proved that NATOFEMIN had strong nattokinase activity .
1 is the artificial thrombus melted by NATOFEMIN and diffused.
(nattokinase activity 1>3> 2> 4)
The photograph offered by Professor
Hiroyuki
Sumi of Kurashiki University of Science and the Arts.
[HOME][PRODUCT] [To FOOD MAKERS] [To DRUG STORES] [ON-LINE SHOPPING] [SAMPLE PRESENT ] [] [about us [mail]